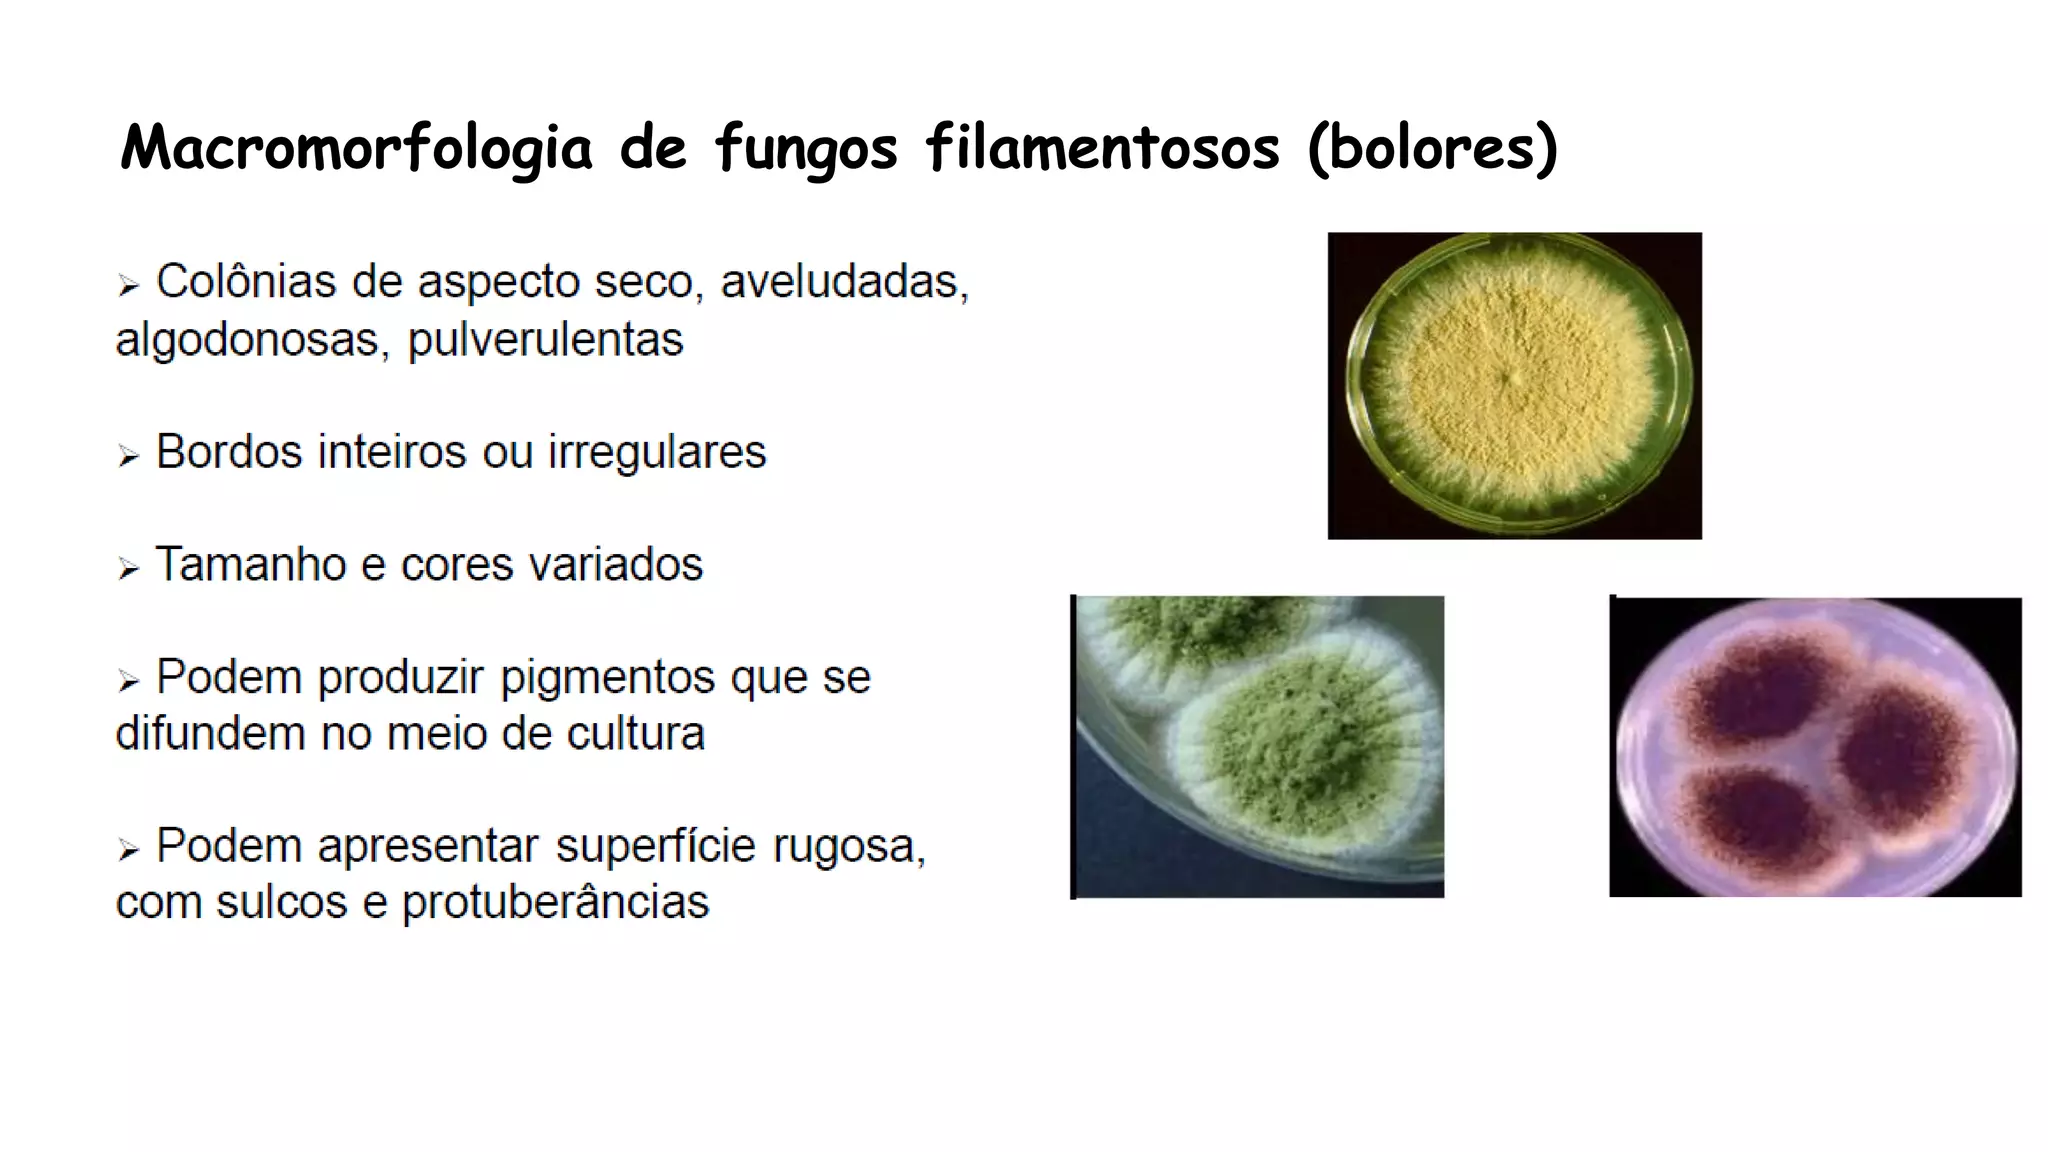
Macromorfologia de fungos filamentosos (bolores)
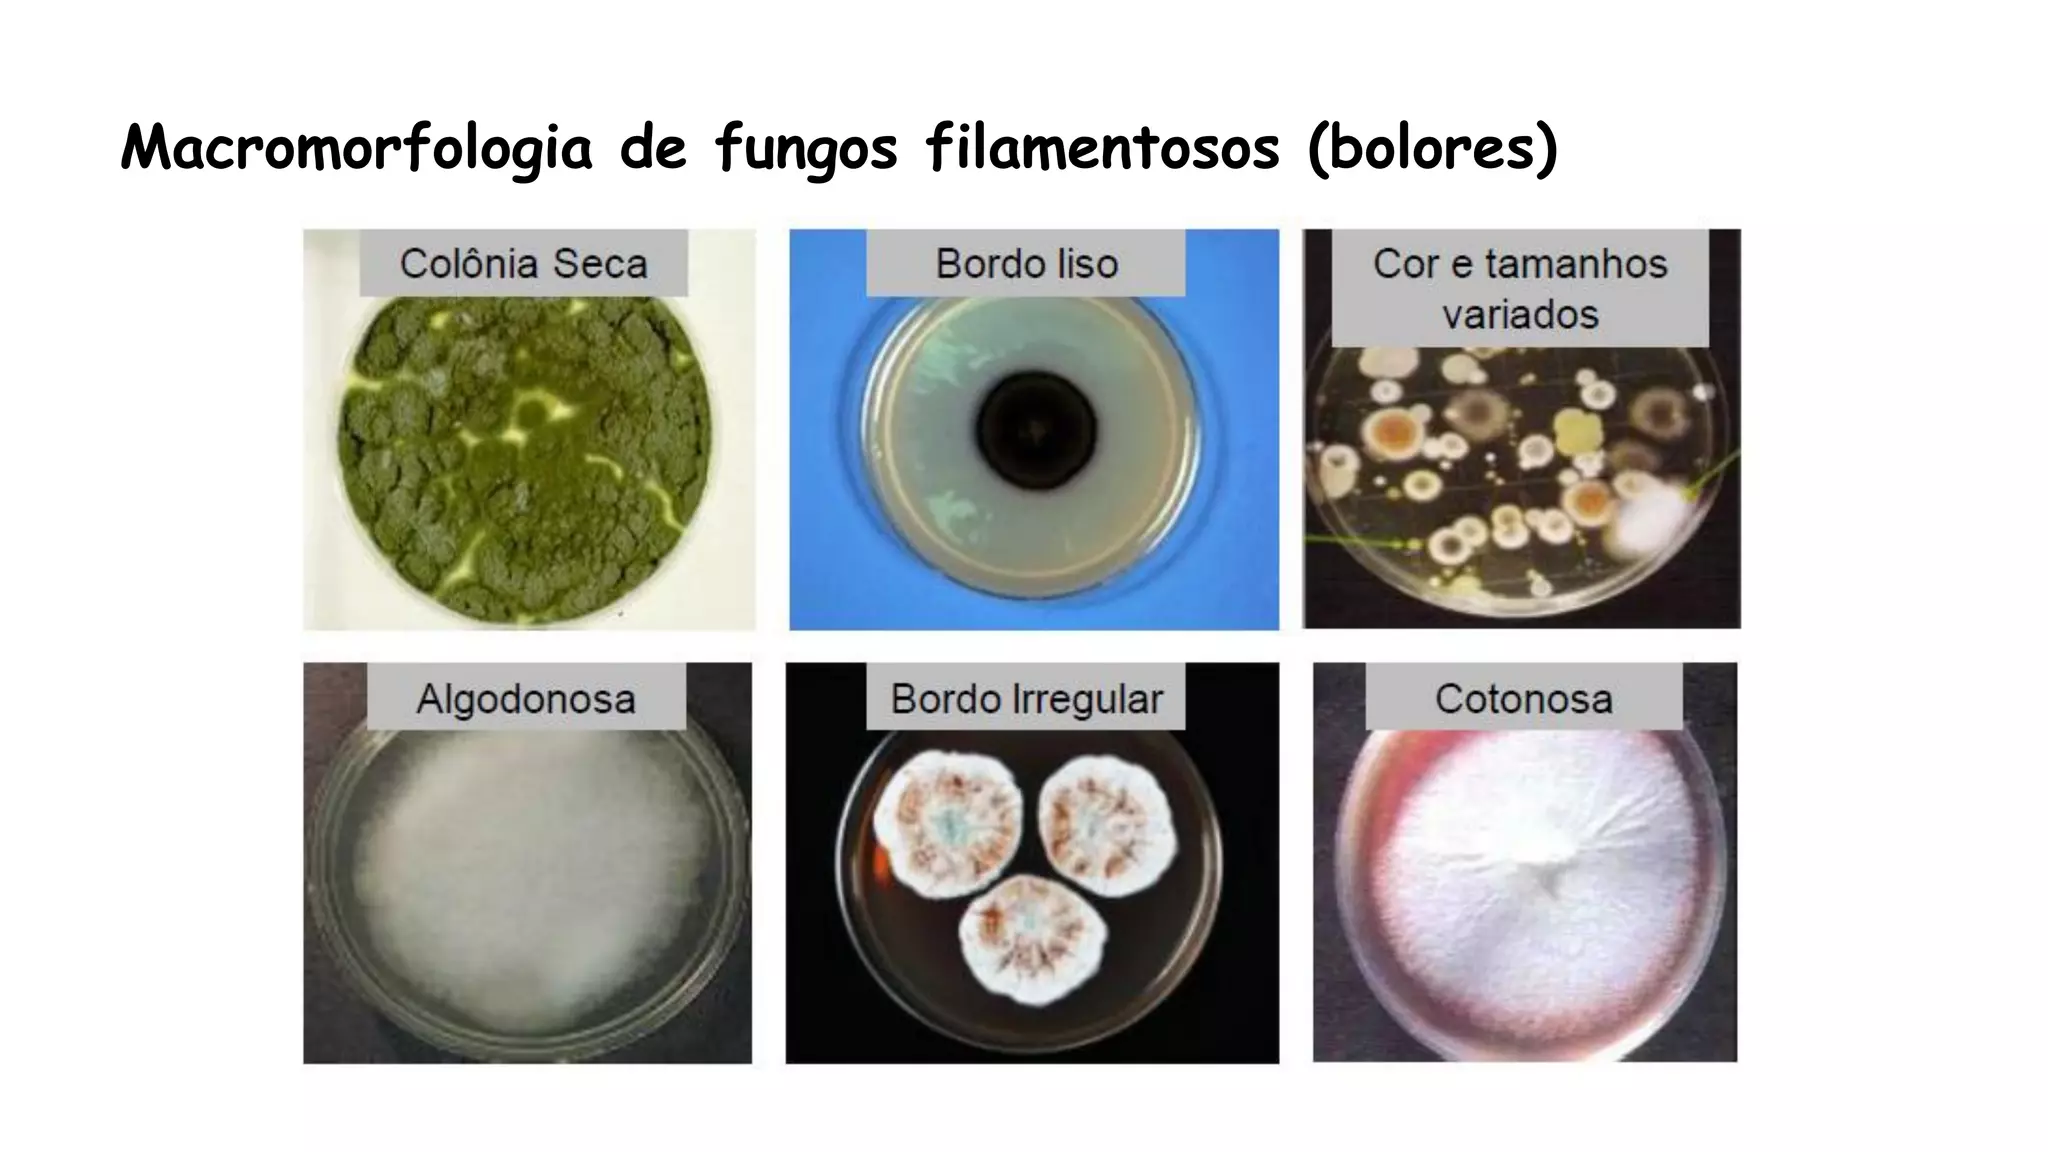
Macromorfologia de fungos filamentosos (bolores)
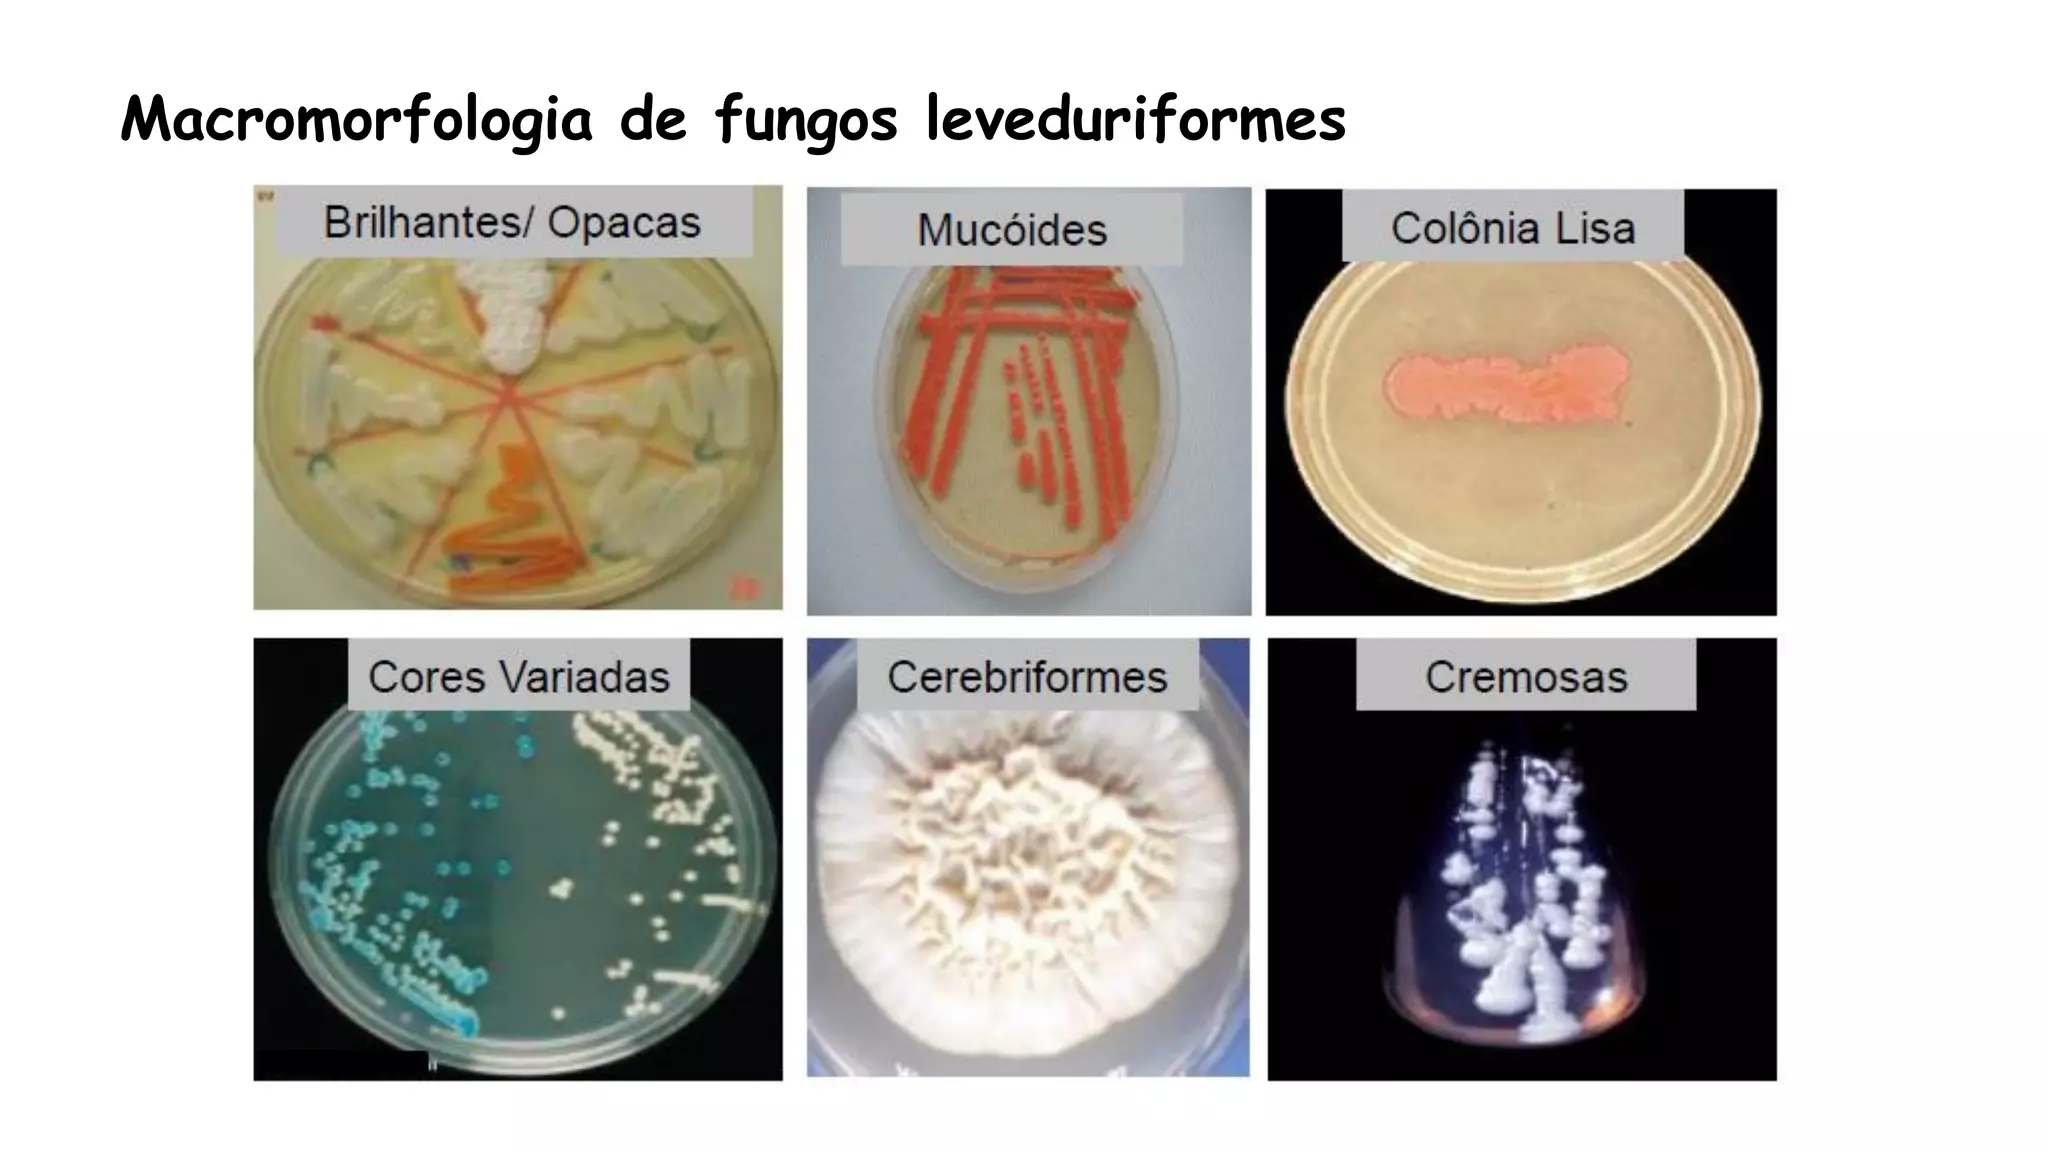
Macromorfologia de fungos leveduriformes

O documento discute a importância médica dos fungos, incluindo que eles podem causar micoses. Detalha como fungos podem ser encontrados em ambientes hospitalares e em pessoas com sistema imunológico comprometido. Também descreve como micoses podem ser classificadas e quais estruturas dos fungos devem ser analisadas para identificação.